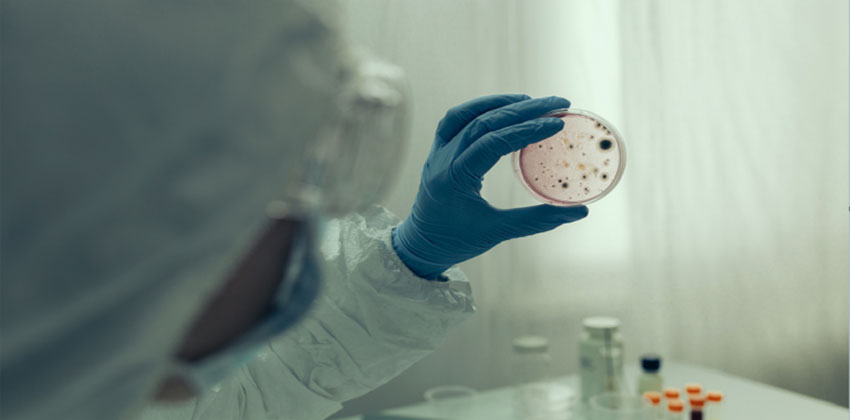
فيروس كورونا

فيروس كورونا يقوم بتغييرات تجعل الخلايا غير قادرة على التعرف عليه
باستخدام رمز الإنذار، يمكننا الدخول إلى المنزل دون أن نقرع الجرس، فهذا
Read More

فيروس كورونا ينتقل جوا أكثر مما كان يعتقد سابقاً ويمكنه التكاثر في الهواء
توصلت دراسة حديثة إلى أن فيروس كورونا يمكن أن ينتشر في الجسيمات المحمولة
Read More

الأطباء في سيبيريا يكتشفون طريقة لقتل فيروس كورونا في 40 ثانية
تم تطوير طريقة فريدة لتدمير مسببات الأمراض الفيروسية في جامعة
Read More

ما المدة التي يعيشها فيروس كورونا في مياه الأنهار؟
ظهرت نتائج دراسة حديثة أجراها علماء من بولندا وبريطانيا، أن فيروس
Read More

أطباء يحذرون من 6 أعراض لفيروس كورونا
لا يزال فيروس كورونا يفاجئ العلماء والأطباء والمرضى بأعراضه وآثاره الجديدة
Read More

عالم روسي: من هو العدو اللدود والصديق الحميم لفيروس كورونا
أشار رئيس مختبر التكنولوجيات البيولوجية في معهد العلوم الكيميائية، فسيفولود
Read More

إدراج مختبرات روسية ضمن المختبرات التي تعمل على دراسة ومكافحة فيروس كورونا
أدرجت منظمة الصحة العالمية، اليوم الثلاثاء، مختبرات روسية رسمية تابعة للهيئة
Read More

حقائق جديدة صادمة عن فيروس كورونا القاتل
قدر باحثون في جامعة هونغ كونغ، وصول أعداد المصابين بفيروس كورونا القاتل في مدينة
Read More
